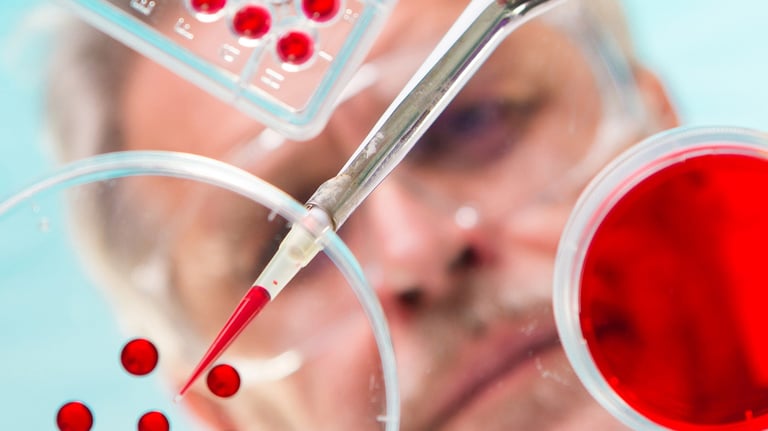
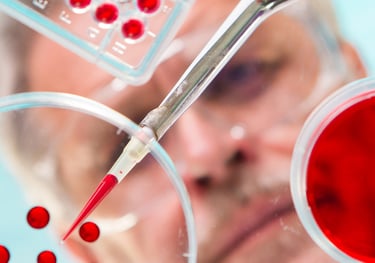

APPLICATIONS
Protect Your Shipments. Ensure Quality.
Identify temperature, impact, or humidity risks before they become costly damage to your critical products.
AyCell Scientific offers advanced cold chain monitoring solutions tailored to industries like pharmaceutical logistics, life sciences, and diabetes care in the UAE, Saudi Arabia, Jordan, and other GCC countries.
Explore how our temperature and impact indicators, including SpotBot GL, WarmMark QR, and ShockWatch 2, help businesses across the Middle East protect sensitive shipments and ensure full supply chain visibility.
Diabetes
A slight temperature excursion can make insulin and related medications ineffective, directly impacting patient health.
Our insulin temperature monitoring devices are trusted across UAE and Jordan to ensure safe insulin transport from distributor to patient, maintaining compliance and peace of mind.
Pharmaceutical
Vaccines, biologics, and medications are highly temperature-sensitive.
A single failure in the cold chain can lead to product loss, health risks, and non-compliance with regulations.
Our tools provide real-time pharma temperature tracking for distributors and healthcare providers in Saudi Arabia, UAE, and the wider GCC.
Life Science
Biological samples, reagents, and lab equipment are extremely sensitive to temperature and humidity fluctuations.
From clinical labs in Dubai to research facilities across GCC countries, our solutions help maintain data integrity and ensure reliable outcomes in life sciences.
Packaging
During transportation, unmonitored shocks and impacts can severely damage fragile or high-value items.
Aycell provides impact monitoring solutions like ShockWatch 2 to detect mishandling and ensure safer deliveries across UAE, Saudi Arabia, and Jordan. These packaging damage indicators are crucial for maintaining supply chain visibility and reducing costly returns.
Food Logistics
ood spoilage caused by poor temperature control is a major risk in GCC food logistics.
Aycell helps ensure proper refrigeration throughout the journey, reducing product loss and supporting HACCP compliance.
Our cold chain monitoring tools are ideal for the transport of produce, meat, dairy, and frozen goods across UAE and Gulf countries.
Medical Devices
Medical equipment requires precise environmental control to maintain functionality and regulatory compliance. Aycell’s tilt indicators, temperature sensors, and impact monitors safeguard diagnostic tools, imaging machines, and other sensitive equipment from transport-related risks.
Trusted by hospitals and clinics across Dubai, Riyadh, and Amman, our devices enhance safety in healthcare logistics.
Not Sure Which Monitoring Solution Fits Your Industry?
Contact us, and our experts will help you find the right monitoring solution.